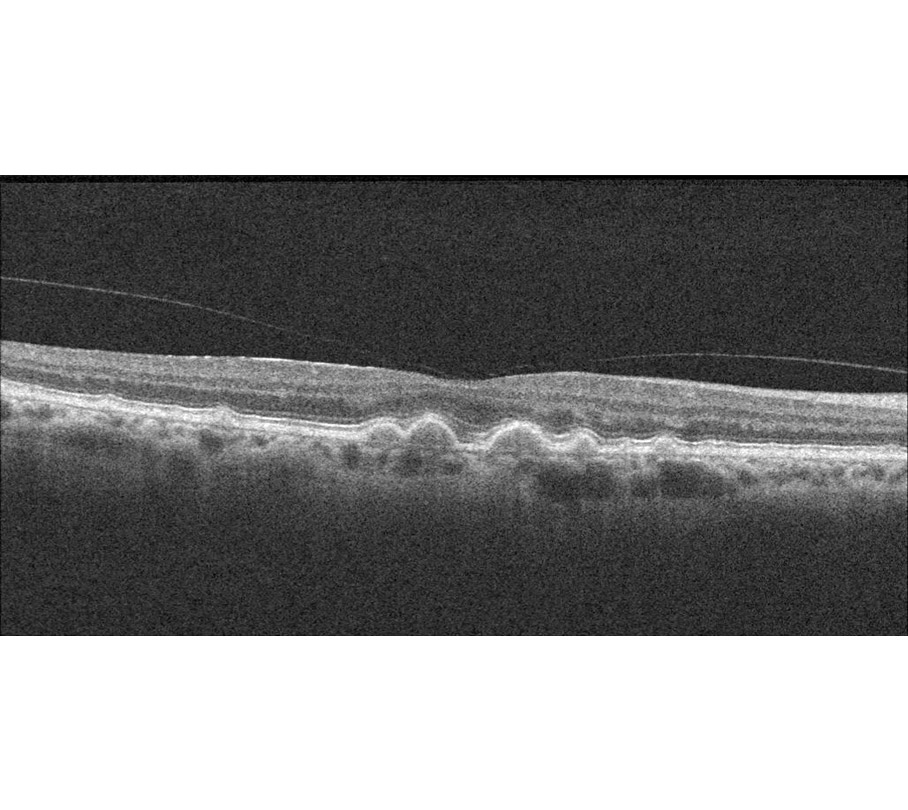

Makuladegeneration

Bild 1: Aufbau des gesunden Auges mit Netzhaut, Sehnerv und Makula

Bild 2: gesunde Netzhaut mit Sehnerv und Makula
Bei der Makuladegeneration werden zwei Formen unterschieden: die häufigere trockene Form und die seltenere, aber aggressivere feuchte Makuladegeneration. Als Abkürzung wird auch der Begriff AMD verwendet (altersbedingte Makuladegeneration).
Trockene Makuladegeneration (Trockene AMD)

Bild: Drusen (abgelagerter Zellmüll) bei trockener Makuladegeneration

Bild: Drusen und Verlust des Pigmentepithels bei fortgeschrittener trockener Makuladegeneration. Sie wird als areoläre AMD oder geographische AMD bezeichnet.
OCT-Bild der trockenen AMD: Ablagerungen (Drusen, „Müllpakete“ unter den Photorezeptoren), kein Ödem
Bei der trockenen AMD handelt es sich um die häufigere Form der AMD, die meist nur langsam fortschreitet und wo man oft mit einer stärkeren Lesebrille oder Lupen helfen kann. Es ist eine altersbedingte Durchblutungsstörung der Netzhautmitte, die zum schleichenden Verlust der Sehkraft im Bereich des schärfsten Sehens, der Makula (auch "gelber Fleck" genannt) führt.
Alltagsbeschäftigungen wie Lesen, Fernsehen, Autofahren oder das Erkennen von Gesichtern werden mit fortschreitender Erkrankung immer weniger möglich. Nur das äußere Gesichtsfeld - und damit die Orientierungsmöglichkeit des Patienten - bleibt bis zuletzt erhalten. Mit einem Bildschirmlesegerät kann man meist noch lange lesen.
Häufigkeit und Verlauf der trockenen AMD
Mit ca. 85 Prozent ist die trockene altersbedingte AMD die weitaus häufigste Form der AMD. Bei dieser Form kommt es über Jahre zur Ablagerung von Zellmüll unter die Schicht der Photorezeptoren und damit zum langsamen Verlust der Photorezeptoren, der lichtempfindlichen Zellen der Netzhaut des Auges, und somit zu einer langsamen Sehverschlechterung bei meist lang erhaltener Lesefähigkeit.
Erstes Anzeichen kann verzerrtes Sehen sein: Gerade Linien erscheinen krumm oder gebogen, Konturen verzerren, Farben werden schwächer. Bald kommen Ausfälle in Form von Flecken hinzu, die sich ausdehnen und fast das ganze Gesichtsfeld, bis auf einen äußeren Kreis, einnehmen können. Wirksame Behandlungsmöglichkeiten sind derzeit noch nicht bekannt.
Amsler-Test bei trockener AMD

Der Amslertest
Der Amslertest hilft bei der Diagnose und Verlaufsbeobachtung von Makulakrankheiten. Die Verzerrung kann eingezeichnet werden und eine Größenzunahme wird damit erkennbar.
Vorbeugen-Vorsorgen
So können Sie selbst einer AMD vorbeugen:
• nicht rauchen,
• regelmäßige körperliche Betätigung,
• Schutz der Augen vor übermäßigem Sonnenlicht,
• vitamin- und ballaststoffreiche Ernährung
(vor allem: Vitamine A, C, E, Karotinoide, Lutein und Spurenelement Zink).
Lutein ist viel in grünem Blattgemüse enthalten.
Vergrößernde Sehhilfen
Beim Lesen hilft mehr Licht (Kontraststeigerung) und Vergrößerung des Textes: Lupen, vergrößernde Sehhilfen, größere Schrift am PC oder beim e-book-reader. Eine „stärkere Brille“ hilft dagegen nicht, es sei denn, man nimmt bei einer stärkeren Lesebrille den geringeren Leseabstand in Kauf.
Augenvitamine und Lutein können ein helfen und sind in richtiger Dosierung und Zusammensetzung zumindest nicht schädlich.
Feuchte Makuladegeneration (feuchte AMD)

Bild: Blutungen und Eiweißaustritt (und Drusen) bei feuchter Makuladegeneration

Schemazeichnung: neugebildete Gefäße wandern von der Aderhaut in die Makula und bluten leicht

Bild: neugebildete Gefäße aus der Aderhaut haben geblutet
Bei der selteneren, aber wesentlich aggressiveren feuchten Form der Makuladegeneration, wachsen krankhafte Blutgefäße in die Netzhaut ein. Sie werden als Neovaskularisationen bezeichnet. Die Gefäßwände werden undicht, Flüssigkeit und Blutbestandteile treten aus.
Als Folge kommt es zu einer fortschreitenden Vernarbung mit Untergang der empfindlichen Nervenschicht (Photorezeptoren) der Netzhaut. Irgendwann ist dieser Prozess unumkehrbar, wenn die Vernarbung zu weit fortgeschritten ist. Die trockene AMD kann, muss aber nicht, in die feuchte AMD übergehen.
Wann ist die Makula trocken, wann feucht?
Wenn sich wegen Sauerstoffmangel unter der Netzhaut durch Aussprossung aus den Aderhautgefäßen neue Gefäße bilden, treten aus den undichten Wänden der neuen Gefäße Flüssigkeit und Blut aus (s. o. im Film). Die tieferen Netzhautschichten schwellen durch diese Flüssigkeitsansammlung an. Es entsteht ein Netzhautödem und manchmal, aber nicht immer, werden Blutungen auf der Netzhautoberfläche sichtbar. Diese Blutungen sind mit dem Augenspiegel sichtbar, nicht aber die zugrundeliegende Membran aus neugebildeten Gefäßen aus der Aderhaut. Die feuchte AMD ist daher am besten durch die OCT (optische Kohärenztomographie) erkennbar, da sie auch die tieferen Schichten der Netzhaut (Ödem) sichtbar macht. Wenn durch Injektionen von gefäßabdichtenden Substanzen die Netzhaut trocken ist, muss man abwarten und durch das OCT beobachten, ob sich erneut Ödeme bilden oder ob die Makula trocken bleibt. Das muss jahrelang beobachtet werden.
Diagnostik der feuchten AMD

feuchte AMD im OCT: Ödem in der tieferen Netzhaut
Behandlung der feuchten AMD
Zur Behandlung der feuchten AMD sind zwei Medikamente zugelassen, die zur Gruppe der Anti-VEGF-Präparate gehören. Sie werden intravitreal gegeben (Injektion in den Glaskörper):
• Ranibizumab (Handelsname Lucentis)
• Aflibercept (Handelsname Eylea)
Beide Medikamente haben ein ähnliches Wirkprinzip: Sie hemmen bestimmte Wachstumsfaktoren, die für das Einwachsen der abnormen Blutgefäße in das Auge verantwortlich sind.
Ziel der Medikamenten-Behandlung ist es, das Fortschreiten der feuchten AMD zu verlangsamen oder zumindest aufzuhalten. Manchmal sind über 30 Injektionen erforderlich. Eine wirkliche Heilung ist damit nicht zu erreichen, nur eine Verzögerung des Krankheitsprozesses.
Unsere Praxis arbeitet für die Durchführung von intravitrealen Injektionen mit mehreren operativen Praxen und Augenkliniken zusammen.
Selbsthilfegruppen für AMD
Ort des Gesprächskreises
Restaurant Split
Blücherplatz 2
10961 Berlin (Kreuzberg)
(Nur wenige Gehminuten von den U-Bahnhöfen Mehringdamm und Hallesches Tor entfernt).
Wer kann teilnehmen
Jeder, der an den oben beschriebenen Themen interessiert ist.
Termine
Jeden 3. Freitag im Monat um 18:00 Uhr.